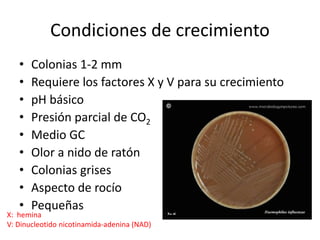
Condiciones de crecimiento
• Colonias 1-2 mm
• Requiere los factores X y V para su crecimiento
• pH básico
• Presión parcial de CO2
• Medio GC
• Olor a nido de ratón
• Colonias grises
• Aspecto de rocío
• Pequeñas
X: hemina
V: Dinucleotido nicotinamida-adenina (NAD)
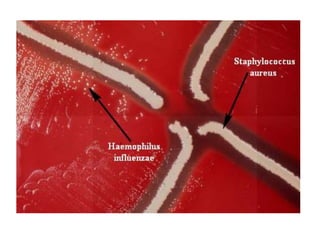
Diagnóstico
• Cultivo
• Aglutinación de partículas de látex (prueba
antigénica)
• PCR
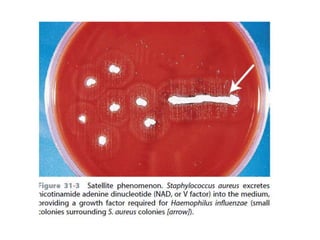

Este documento describe el género Haemophilus, en particular la especie Haemophilus influenzae. Explica que requieren factores como hemina y NAD para su crecimiento. También describe las características, patogenia, enfermedades asociadas como meningitis e infecciones respiratorias, y el diagnóstico y tratamiento de H. influenzae.